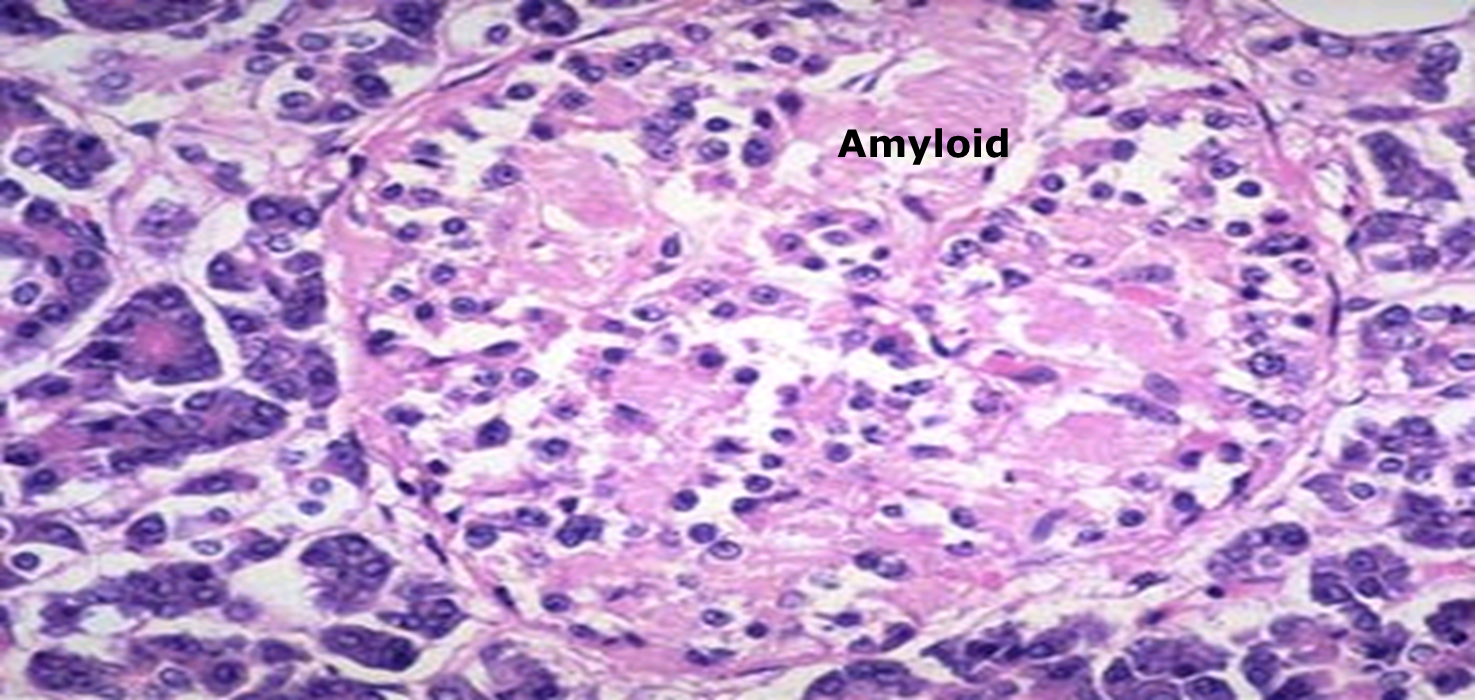

FM
Definition
Type 2 diabetes mellitus is a progressive disorder defined by deficits in insulin secretion and increased insulin resistance that lead to abnormal glucose metabolism and related metabolic derangements.
Prevention in General Practice
- Presenting complaint overt/covert
- Continuing care
- Coordination of care
- Modification of abnormal help-seeking behaviour
- Prevention, early detection, health promotion
Historical Perspective
- Those labouring with this Disease, piss a great deal more than they drink. Authors who affirm the drink to be little or nothing changed are very far from the truth, because the urine very much differed both from the drink taken in and also in being wonderfully sweet as if it were imbued with honey or sugar.
THOMAS WILLIS (1621ā1675), THE PISSING EVIL
Epidemiology
-
Diabetes prevalence is increasing worldwide, compounded by population growth and an ageing population.
- In 1980, the global age-standardised diabetes prevalence was 4.3%.
- In 2019, diabetes prevalence was estimated at 8.3%.
- Most cases of diabetes (around 90%) are type 2.
-
In some countries, there is a downward trend due to public health education and preventive strategies.
-
Patients with type 2 diabetes have a very high risk of: Z
- Concurrent hypertension (80% to 90%) Z
- Lipid disorders (70% to 80%)
- Overweight or obesity (60% to 70%)
-
When diabetes is diagnosed at age 40 years:
- Men lose an average of 5.8 years of life.
- Women lose an average of 6.8 years of life.
- This highlights the importance of primary prevention of diabetes.
-
Onset of diabetes at older ages has much less effect on life expectancy if acceptable glucose, blood pressure, and lipid control can be achieved and maintained.
Risk Factors
General Risk Factors
-
Older age
Older patients are at increased risk. However, the incidence of type 2 diabetes in children and adolescents is increasing. -
Overweight/obesity
Appears to be the precipitating factor leading to clinical expression of diabetes. The mean body mass index (BMI) at the time of diagnosis of diabetes in several studies is around 31 kg/m², and there is a graded increase in risk of diabetes with increasing BMI. -
Gestational diabetes
About 50% of women who have gestational diabetes mellitus will go on to develop overt diabetes mellitus within 10 years of delivery. -
Non-diabetic hyperglycaemia
Non-diabetic hyperglycaemia (sometimes termed pre-diabetes) is a major risk factor for onset of type 2 diabetes. -
Family history of type 2 diabetes
Although the specific genetic profile that confers risk has yet to be fully elucidated, epidemiological observations leave little doubt of a substantial genetic component. -
Non-white ethnicity
Prevalence of diabetes varies by ethnic group. In the UK, type 2 diabetes is more common in people of African, African-Caribbean, and South Asian family origin due to an interplay of diet, lifestyle, and genetic factors. -
Polycystic ovary syndrome
Elevated risk; should be periodically screened for diabetes. -
Hypertension
Often associated with type 2 diabetes. Periodic screening is recommended in people with essential hypertension due to increased prevalence of diabetes. -
Dyslipidaemia
Especially with low high-density lipoprotein (HDL) and/or high triglycerides: periodic diabetes screening is recommended due to the high prevalence of diabetes in patients with dyslipidaemia. -
Cardiovascular disease
High prevalence of diabetes in patients with peripheral vascular and coronary artery disease. -
Stress
Stress provokes release of hormones that elevate glucose, and there is some evidence that life stress may predispose to onset of type 2 diabetes.
Thera
Diabetes Mellitus (DM) is a group of metabolic disorders characterized by
chronic hyperglycemia caused by
-
defects in Insulin secretion
-
defects in insulin action
-
Or both
-
Classification of Diabetes Mellitus
-
Biochemical Basis of clinical Manifestation of DM
-
Laboratory Diagnosis of DM

Insulin Hormone Structure
-
Insulin is a 51 amino acids protein hormone composed of two chains, A and B
-
Linked together by two disulfide bonds.
-
The A chain consists of 21 amino acids.
-
The B chain consists of 30 residues.
-
In the stored form, the two chains connected by C- peptide
-
Half-lives
-
The insulin and C-peptide are secreted in equimolar concentration.
-
Insulin has a short plasma half-life of 4-6 minutes.
-
This is because insulin needs to respond rapidly to changes in blood glucose.
-
The half-life of C-peptide is around 30 to 35 minutes.
-
The C-peptide used to measure the endogenous insulin secretion
Physiology of Insulin
Stored insulin
What is the importance of C-peptide level measurement?
Giving insulin level secretion

Insulin hormone
What is the importance of insulinĀ level measurement?
Insulin Resistance measurement

Clinical disturbance due to insulin impairment
- Diabetes mellitus
- Insulin resistance
- Hyperinsulinemia
- Metabolic syndrome
Hormones that increase IR responsiveness and related Ā diseases
- Growth hormone ā Acromegaly
- Cortisol ā Cushing Syndrome
- PRL ā Hypogonadism
- Gonadal steroids ā PCOS
Discussion
Why is insulin necessary physiologically? Why is insulin imbalance substantial clinically? insulin is dependent to satiety levels, any disturbance would cause constant hunger without substation (Polyphagia)
(Polyuria) Hyperglycemia, Hyperosmolarity, Glucose transporter 3 or 1 maximum
-
Treat underlying causes by reducing weight and increasing physical activity
-
Treat cardiovascular risk factors if they persist despite lifestyle modification
Keywords abstract
-
impaired glucose tolerance (IGT) ānot diabeticā
-
NIDDM & Approx. 25% of nonobese individuals with normal glucose tolerance
-
Deterioration of glucose tolerance can only be prevented if beta-cell can increase its insulin secretory response and maintain a state of chronic hyperinsulinemea
-
Gross decompensation of glucose homeostasi occurs
-
Insulin supression of plasma insulin level, and glucose intolerence
-
Patients with NIDDM are also resistant to insulin supression of plasma FFA conentration.
-
FFA concentration elevations can be prevented if large amount of insulin can be secreted. - Free FFA results in Increased Hepatic Glucose production resulting in significant fasting hyperglycemia under these conditions
-
Hypertensive patients treated or untreated are insulin resistant, hyperglycemic, and hyperinsulinemic - a direct relationship between plasma insulin concentration and blood pressure has been noted.
-
Fructose-enriched diet in rats, lead to development of insnulin resistance and hyperinsulinemia.
Acute complications:
- Diabetic keto-acidosis (DKA)
- Hypoglycemic coma
Chronic Complications of diabetes mellitus
- Diabetic macroangiopathy
- Diabetic microangiopathy
Diagnostic criteria for diabetes mellitus
| diagnosis | fasting blood sugar | Glucose tolerance test (after 2 hours) | HbA1c |
|---|---|---|---|
| Normal | ﹤100mg/dL | ﹤140mg/dl | ﹤5.7ļ¼ |
| Prediabetic | 100-126 mg/dL | 140-199/dL | 5.7-6.4ļ¼ |
| Diabetic | ﹄ 126mg/dL | ﹄200mg/dL | ﹄6.4 % |
Type 1 VS 2
| Type I diabetes | Type II diabetes | |
|---|---|---|
| 1.clinical | Onset:childhood. Normal weight or weight loss | Above 40 years. -obesity |
| 2. Etiology | 1. Hereditary as it linked to MHC class I&II 2.Autoimmune inflammation with destruction of the B.cells by circulating autoantibodies due to failure of tolerance to self antigens | 1. Not linked to MHC antigens. 2. No islet autoantibodies 3. There is prepheral resistance to insulin enhanced by cytokines released from adipose tissue that mask insulin receptors. |
| 3. B. Cell mass. | InsulitisĀ with lymphocytic infiltration causing early b cell depletion and atrophy of them leading to Progressive decrease in insulin level . | normal in early stage as no insulitis, later on shows amyloid deposition with mild B cell depletion. |
Pancreatic islets in type II DM - H &E stain(Islet shows extensive deposition of amyloid)
- Complications of diabetes mellitus: